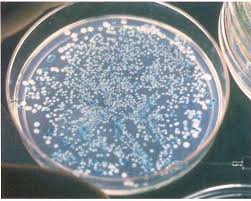

Bacterial Development
Bacterial development alludes to an expansion in cell numbers as opposed to an expansion in cell size. The cycle by which bacterial cells separation to recreate themselves is known as twofold cross over parting. The time taken from cell development to cell division is known as the age time. The age time can along these lines be characterized as the time taken for the cell check to twofold.
The bend appeared in Figure 9 shows the periods of bacterial development following vaccination of microscopic organisms into another development medium. The accompanying stages can be distinguished:
1. Lag stage: There is generally some deferral in development following vaccination of microbes into another medium, during which time the microorganisms adjust to the medium and orchestrate the catalysts expected to separate the substances in the development medium.
2. Log stage: Once the microbes have adjusted to the new medium they begin to imitate rapidly and their numbers increase equally for every addition of time. A plot of the log number of cells against time gives a direct relationship: this is thusly called the log stage. The cells are at their most noteworthy action in this stage. Moving societies to a new medium at customary spans can keep up the cells in a functioning state. A functioning society can quickly overwhelm any new condition.
3. Stationary stage: As the microbes overwhelm the development medium, they drain the accessible supplements or harmful material items gather, easing back the pace of multiplication. Simultaneously, cells are vanishing: A condition of harmony is reached between the passing of old cells and arrangement of new cells, bringing about no net change in cell numbers. This stage is known as the fixed stage.
4. Death stage: In the following stage the development of new cells stops and the current cells progressively cease to exist: This is known as the passing stage.
5. The log stage can be drawn out by eliminating harmful material, by including more supplements or both.
The log stage can be drawn out by eliminating harmful material, by including more supplements or both.
The log stage can be drawn out by eliminating harmful material, by including more supplements or both.
Bacterial development is the a biogenetic propagation, or cell division, of a bacterium into two girl cells, in a cycle called paired splitting. Giving no mutational occasion happens the subsequent girl cells are hereditarily indistinguishable from the first cell. Thus, “nearby multiplying” of the bacterial populace happens. Both girl cells from the division don’t really endure.
Be that as it may, if the number enduring surpasses solidarity all things considered, the bacterial populace goes through exponential development. The estimation of an exponential bacterial development bend in clump culture was generally an aspect of the preparation, everything being equal; the essential methods requires bacterial identification (cell checking) by immediate and individual (tiny, stream cytometry, direct and mass (biomass), backhanded and singular (province tallying), or roundabout and mass (most plausible number, turbidity, supplement take-up) strategies. Models accommodate hypothesis with the measurements.
Bacterial Development Bend
In bacteriological examinations, the development of microscopic organisms (or different microorganisms, as protozoa, microalgae or yeasts) in cluster culture can be demonstrated with four distinct stages: slack stage (A), log stage or exponential stage (B), fixed stage (C), and demise stage during slack stage, microorganisms adjust to development conditions. It is where the individual microscopic organisms are developing and not yet ready to separate. During the slack period of the bacterial development cycle, amalgamation of RNA, proteins and different atoms happens.
1. The log stage (in some cases called the logarithmic stage or the exponential stage) is a period described by cell doubling.The quantity of new microorganisms showing up per unit time is relative to the current populace. On the off chance that development isn’t restricted, multiplying will proceed at a consistent rate so both the quantity of cells and the pace of populace increment copies with each sequential time span.
For this sort of exponential development, plotting the regular logarithm of cell number against time delivers a straight line. The slant of this line is the particular development pace of the creature, which is a proportion of the quantity of divisions per cell per unit time.The genuine pace of this development (for example the incline of the line in the figure) relies on the development conditions, which influence the recurrence of cell division occasions and the likelihood of both girl cells enduring.
Under controlled conditions, cyanobacteria can twofold their populace multiple times a day. Exponential development can’t proceed uncertainly, be that as it may, on the grounds that the medium is before long exhausted of supplements and advanced with squanders.
2. The fixed stage is regularly because of a development restricting component, for example, the exhaustion of a basic supplement, or potentially the arrangement of an inhibitory item, for example, a natural corrosive. Fixed stage results from a circumstance in which development rate and demise rate are equivalent. The quantity of new cells made is restricted by the development factor and therefore the pace of cell development coordinates the pace of cell demise. The outcome is a “smooth,” flat straight aspect of the bend during the fixed stage.
3. At passing stage (decay stage), microscopic organisms pass on. This could be brought about by absence of supplements, natural temperature above or beneath the resilience band for the species, or different damaging conditions.
This fundamental bunch culture development model draws out and underscores parts of bacterial development which may vary from the development of macrofauna. It underlines clonality, agamic twofold division, the short advancement time comparative with replication itself, the apparently low passing rate, the need to move from a lethargic state to a regenerative state or to condition the media, lastly, the propensity of lab adjusted strains to debilitate their supplements. In all actuality, even in bunch culture, the four stages are not all around characterized.
The cells don’t repeat in synchrony without express and nonstop provoking (as in explores different avenues regarding followed microscopic organisms and their exponential stage development is regularly not ever a steady rate, however rather a gradually rotting rate, a consistent stochastic reaction to compels both to repeat and to go torpid even with declining supplement focuses and expanding waste fixations.
Cluster culture is the most widely recognized lab development technique in which bacterial development is examined, however it is just one of many. It is in a perfect world spatially unstructured and transiently organized. The bacterial culture is hatched in a shut vessel with a solitary bunch of medium. In some trial systems, a portion of the bacterial culture is intermittently eliminated and added to new clean medium.
In the extraordinary case, this prompts the consistent reestablishment of the supplements. This is a chemostat, otherwise called persistent culture. It is in a perfect world spatially unstructured and transiently unstructured, in a consistent state characterized by the paces of supplement flexibly and bacterial development. In contrast with bunch culture, microscopic organisms are kept up in exponential development stage, and the development pace of the microorganisms is known. Related gadgets incorporate turbid stats and auxo stats.
Bacterial development can be stifled with bacteriostats, without essentially executing the microscopic organisms. In a sync logical, consistent with nature circumstance in which more than one bacterial animal varieties is available, the development of microorganisms is more powerful and persistent.
Fluid isn’t the main research center condition for bacterial development. Spatially organized conditions, for example, biofilms or agar surfaces present extra complex development models.

Very very impressive. Waiting for next post.
very informative , very nice are you a microbiologist
good
Wow, I love this article specially because I'm into scientific stuffs.
Very good post about bacterial growth and development. Highly informative. Keep up the good work.